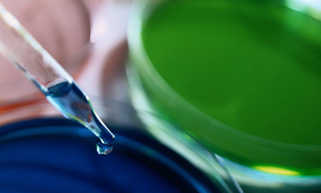

our products
-------

Medical inspection consumables
Inspection supplies are manufactured from high quality material for opticl products , apply to the full automatic biochemicl analyzer and coagulometer.With excellent transparency;high strength;corrosion resistance and excellent surface finish.
-
Precision Moulds
Heall has one professional work team which engaged in the mould making . meanwhile,we convene a group of well trained and experienced workers at the production line,Heall possess high-tech production equipments, reduce the work intensity and improves the work efficiency.
-

fully automatic coagulation analyzer
Performance advantages HL series fully automatic coagulation analyzer has the measuring principles of the coagulation method, immunoturbidimetric method, and chromogenic substrate method. The pursuit of ease of use and operability, with rich help functions, a full support system to ensure data...
about company
-----
Heall Enterprises Canada Ltd was incorporated on June 22, 2015,Based on modern management theories,Heall specializes in developing,manufacturing and marketing of disposable medical consumables and precision moulds for clinical inspection and biochemical laboratory works.
 hotline:+1(778)881-1167
hotline:+1(778)881-1167














